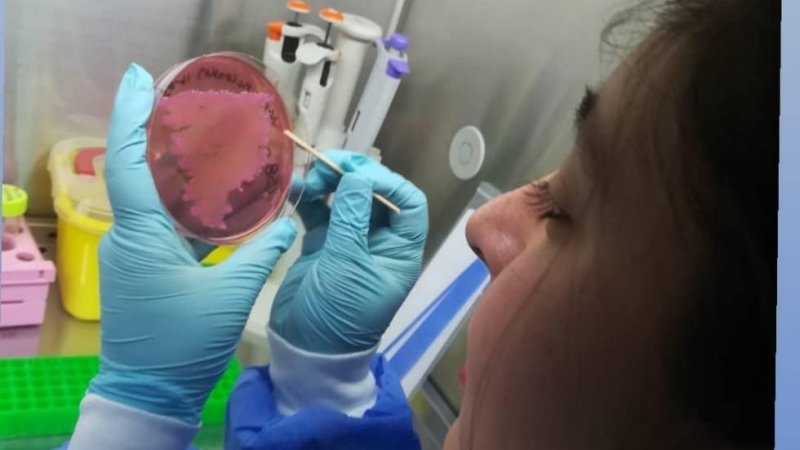

Viernes 16 de Octubre de 2020
La estudiante de Tecnología Médica Vanessa Bustamante participó en dos artículos de investigación, encabezados por el Dr. Christian Palavecino.
"Para mi significó mucho poder entrar al área de investigación y participar de forma activa y concreta en este proyecto del profesor Christian Palavecino, ya que aprendí a utilizar técnicas que no se utilizan normalmente en clínicas", orgullosa y agradecida de lo logrado, la estudiante de Tecnología Médica Vanessa Bustamante, nos cuenta de cómo ha sido su experiencia de poder participar en dos investigaciones a su corta edad.
“The mode of action of the PSIR-3 photosensitizer in the photodynamic inactivation of Klebsiella pneumoniae is by the production of type II ROS which activate RpoE-regulated extracytoplasmic factors” y “Photodynamic treatment with cationic Ir(III) complexes induces a synergistic antimicrobial effect with imipenem over carbapenem-resistant Klebsiella pneumoniae”, son los nombres de los artículos que que consiste en el mecanismo de acción de la terapia fotodinamica con un compuesto fotosensibilizador de irilio III en klebsiella pneumoniae productora de carbapenemasas.
“Visualizamos que la multiresistencia a antibióticos es un problema real y actual en diferentes microorganismos, en donde nos centramos en klebsiella pneumoniae productora de carbapenemasas. Klebsiella pneumoniae es una bacteria bacilo gram negativo que causa infecciones en el trato urinario y enfermedades Nosocomiales respiratorias donde en esta última demostraba tener resistencia a penicilinas, cefalosporinas y además carbapenemicos. En base a esa problemática empezamos a investigar la terapia fotodinamica con compuestos fotosensibilizadores como el Irilio III para poder lograr un efecto bactericida por medio del estrés oxidativo para ver si se producía algun efecto de permeabilidad de membrana, para todo este proceso utilizamos diferentes técnicas en donde expusimos por triplicado a las cepas KPPR1 y ST258 (resistente) a concentración determinadas de compuesto fotosensible de irilio e imipinem , dejando un grupo control solo con el antibiótico luego dejandolas 1 hora en ausencia de luz y luego exponiendolas por una hora a una luz en condiciones controladas”, explicó la estudiante de Tecnología Médica con mención en Bioálisis Clínico, Hematología y Banco de Sangre.
Bustamante cuenta que en los experimentos, que tuvieron excelentes resultados, utilizaron diferentes materiales y métodos con los que contaban en el Centro de Investigación de la UCEN. Estos artículos fueron publicados en la revista científica ELSEVIER.
“Además de estar totalmente agradecida del profesor Christian Palavecino por la entrega y trabajo continúo que realizamos en conjunto donde su apoyo, guía y enseñanzas constantes hicieron que fuera mejorando muchas de mis debilidades y aprendiendo de forma correcta la aplicación de la materia y el uso de diferentes reactivos y materiales del laboratorio. Personalmente siempre me gusto mucho esta área, por ende me siento bastante feliz con poder ver mi nombre en dos papers y ver que puedo incluso encontrar estas publicaciones usando mi nombre en plataformas como "pubmed"”

